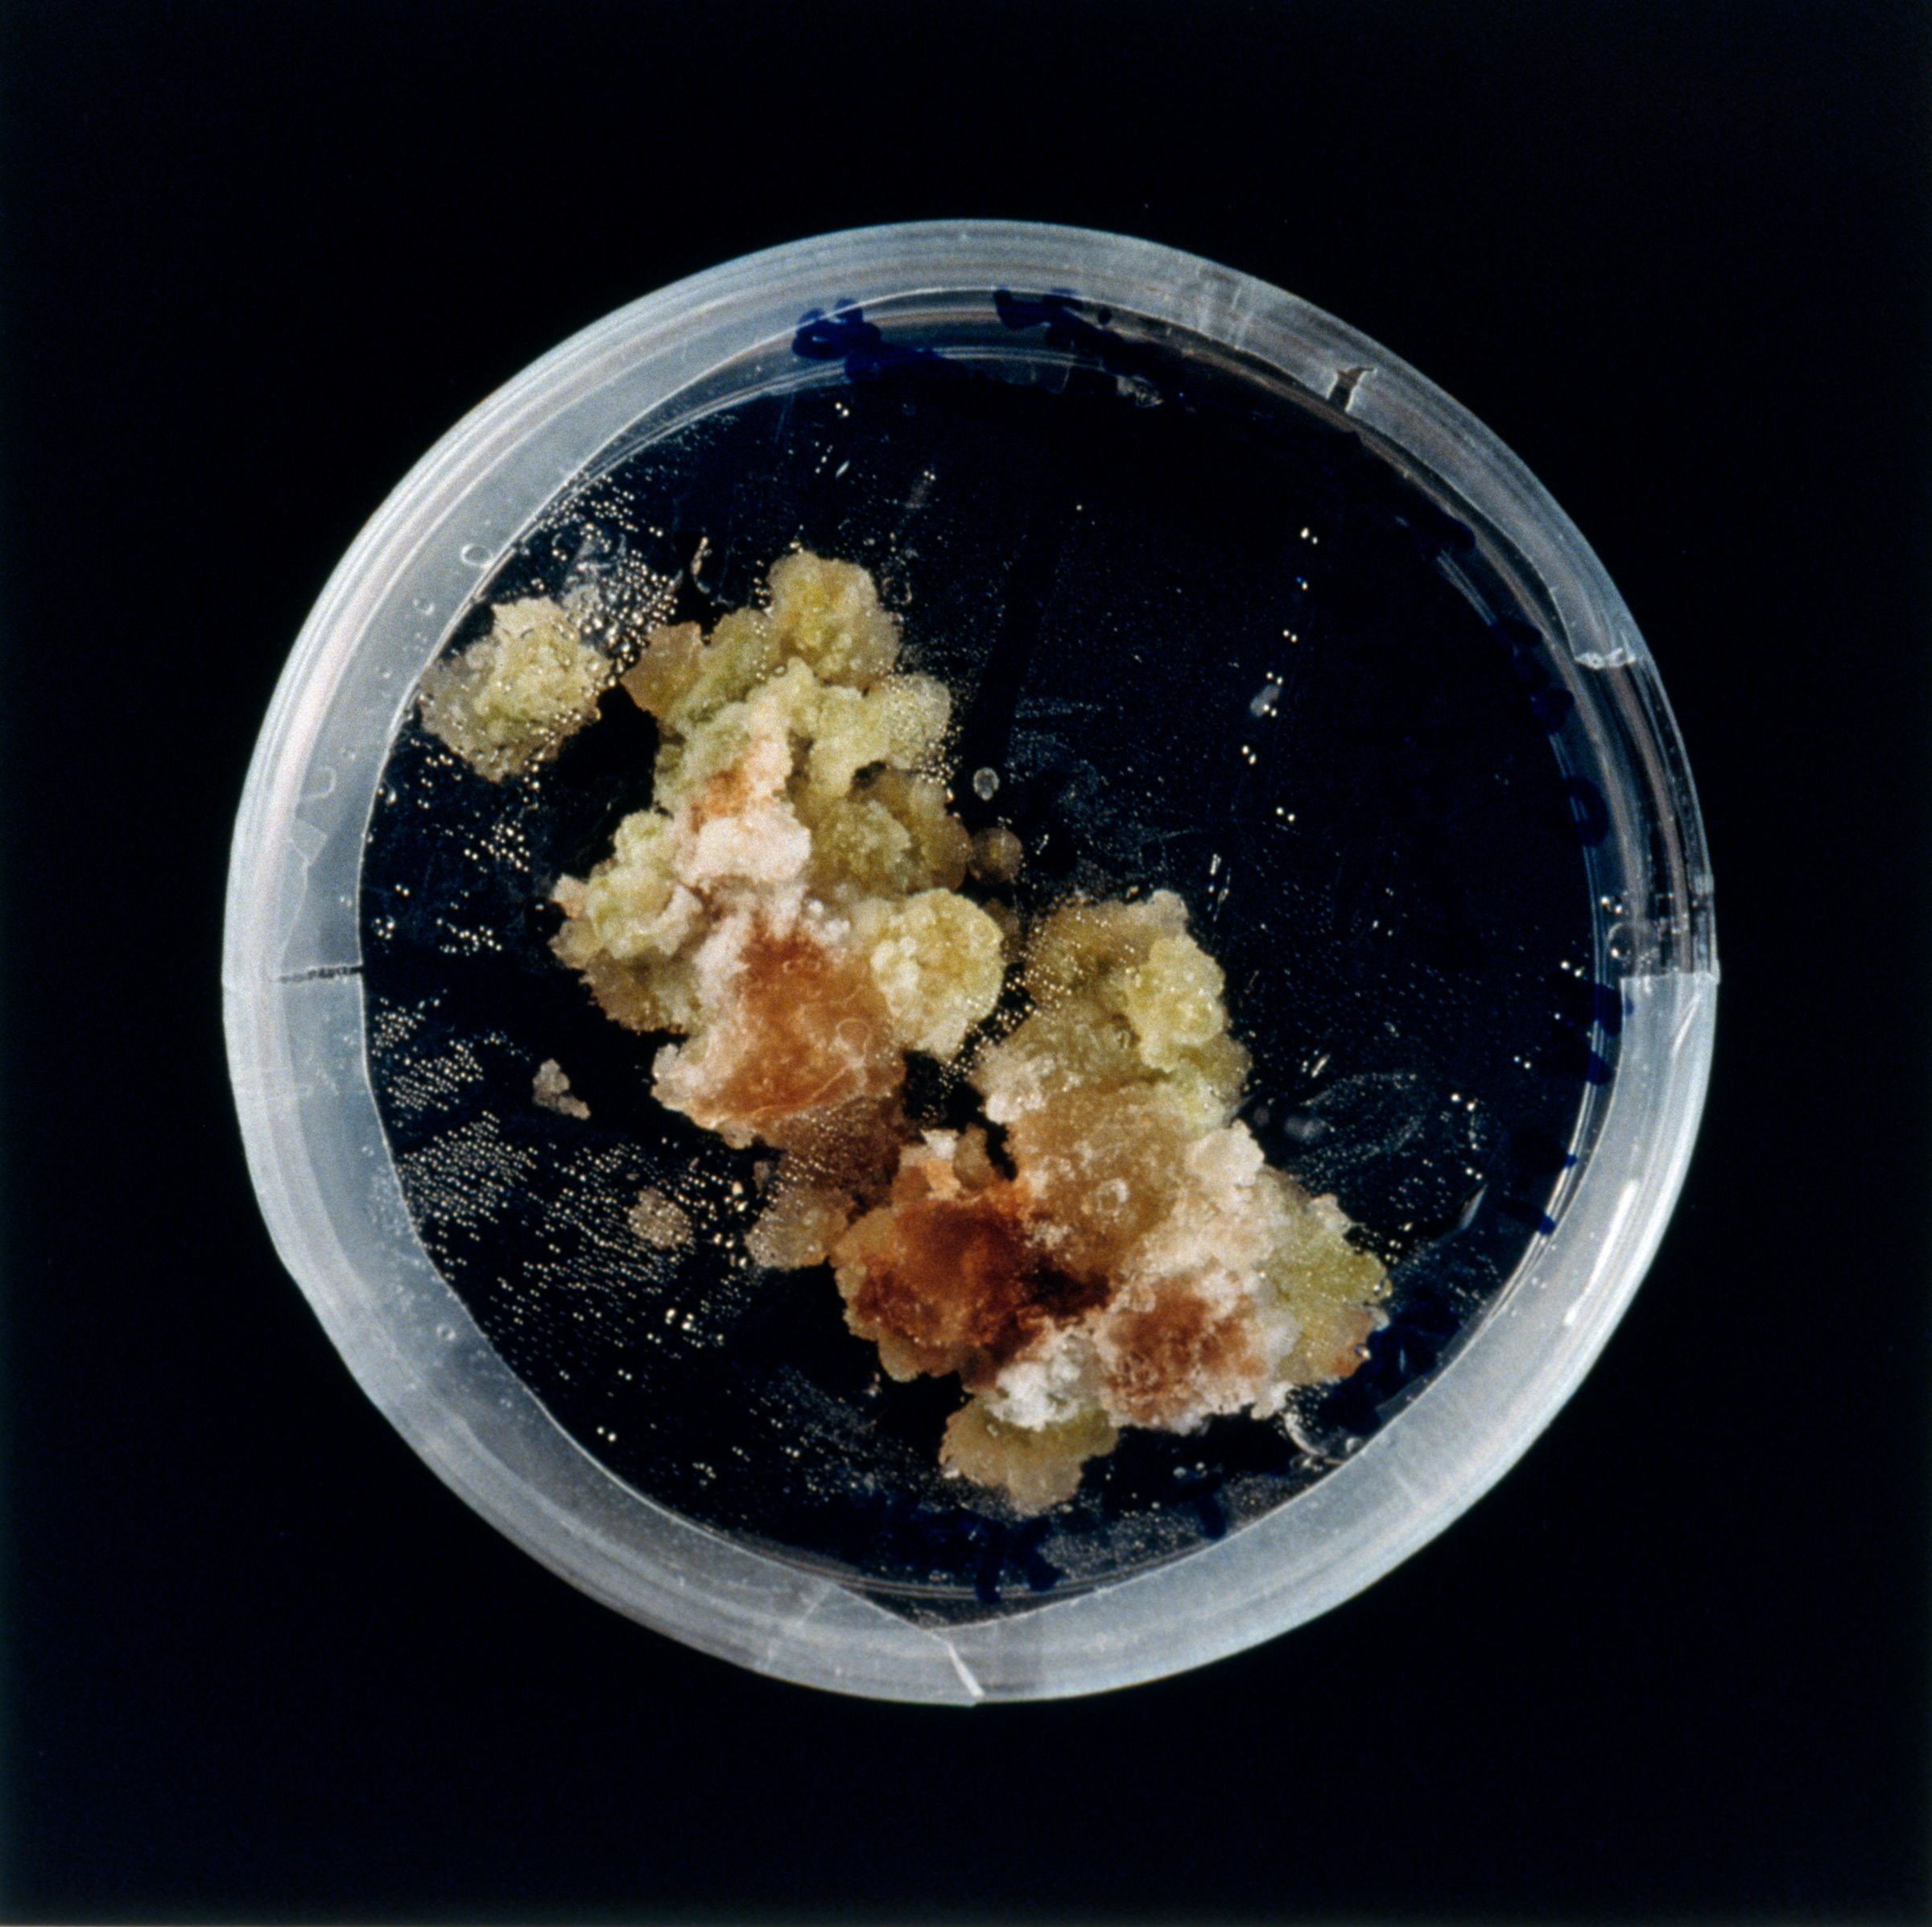

Deviation From Normal
It‘s simple to perturb the systems we call “plants,” and no one seems to mind, unlike with animals. And plants are so cooperative. They just keep growing, any way they can, as long as they are alive, inexorably, like ticks moving toward a host. Pinch them and they branch; deny them light and they grow on reserves, restrict water and they grow slower and smaller. Crowd them into a small space and they grow straight up; give them room and they fill it with branches. Plants respond to light, dark, gravity, touch, predation, and crowding, in exquisite and constant feedback with their environment.
By precise perturbation and observation, botanists accumulate facts and put forth hypotheses (stories) about the life of plants. Some experiments are so definitive in the construction of these stories they become classics and are widely repeated in the science classroom. The same species of plants are grown over and over, the same manipulations performed upon them as pivotal experiments are replayed. Like circus trainers, we induce our subjects to perform their well-rehearsed tricks. But after the show is over and the audience has gone home, the experimental plants grow on. In Deviation From Normal, I am interested in how such manipulated plants continue to grow, in individuality vs. similarity, in the way components form wholes, in the way science is constrained by logic.
Works
Dark Matter
Parenchyma cells from many plants, including tobacco, will de-differentiate and form a mass of callus tissue when isolated and grown sterilely on nutrient medium. After a time, the chunks of callus can be transferred to media containing growth hormones that induce the tissue to produce shoots or roots. As the ratio of two such plant hormones is systematically changed, the appearance of the callus changes. The petri dishes in Dark Matter are an actual data grid of increasing BA (for shoots) in the horizontal direction, and increasing NAA (for roots) down the vertical direction.
Etiolated
Seedlings for physiology experiments are often grown in the dark where they fail to develop their light-gathering pigments. The seedlings are etiolated: elongated, pale, with tiny leaves. Large-seeded species, such as corn, beans, sunflowers, oats, and peas, can live for two or three weeks in the dark, if they have water. But without chlorophyll, they cannot photosynthesize and quickly die when the stored food from the seed is exhausted.
Manipulated
A plant stem grows faster on the side facing away from a light source, and hence, bends toward the light. A classic experiment demonstrates that a plant hormone causes this differential growth. A dab of lanolin paste containing the hormone is applied to one side of a corn plant grown in the dark. Within hours, the growing plant curves exactly as if it were receiving unilateral light. Lanolin paste without the hormone has no effect. The effect of the hormone on the growth of the treated plants is exerted for several days.
Squash
Squash seeds appressed with moist cotton to the glass of a petri dish, always germinate with the roots growing down. This makes a dandy demonstration of the fact that roots grow toward a gravitational field, a phenomenon called gravitropism. If the petri dishes are taped to a slowly-rotating vertical wheel, the direction of gravity is constantly changing for the seeds inside, and the emerging roots grow in a circle. Shoots also respond to gravity: they grow in the opposite direction, exhibiting negative gravitropism.
Roots
Radish seeds are germinated in the dark, on filter paper in petri dishes, so that students can see the root hairs on the new roots. This takes about three days. After another week in the light, the seedlings are expanding leaves and pressing against the top of the dishes; the roots are a tangled mess without obvious hairs.
Substitution
A plant hormone (IAA) produced in shoot tips and leaf blades both suppresses lateral bud development (branching) and prevents leaf abscision (leaf fall). The Coleus plants were “decapitated” (shoot tips removed) and de-bladed. In various combinations, the excised organs were replaced by either plain lanolin paste or lanolin paste containing the hormone. After three weeks, the condition of the plants reveals the treatment given to each.
Carol Selter
2000/2003